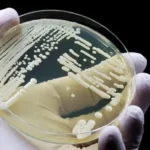

Индия запускает Aditya-L1 для изучения Солнца при поддержке ЕКА
После успешного завершения лунной миссии «Чандраян-3» и посадки на Луну космического аппарата «Викрам» Индия готовится сделать еще один большой шаг в изучении Солнца. 2 сентября 2023 года в 9.20 утра по московскому времени запланирован запуск спутника Aditya-L1 — первой миссии ISRO, предназначенной для наблюдения за Солнцем.
Aditya-L1 будет выведен на неустойчивую орбиту вокруг точки Лагранжа L1 системы Солнце-Земля, расположенной на расстоянии около 1,5 млн. км. Такое выгодное положение позволит спутнику постоянно наблюдать за Солнцем, не заслоняясь затмениями и другими помехами.
Миссия: аппаратура и задачи
Спутнику Aditya-L1 потребуется около 109 земных суток после запуска, чтобы выйти на орбиту вокруг точки L1. Спутник массой 1500 кг будет находиться на орбите в течение номинальной продолжительности 5,2 года.
Спутник оснащен семью современными научными приборами, которые позволят изучать различные аспекты Солнца. Четыре из них будут наблюдать Солнце напрямую. Они будут посвящены динамике верхней атмосферы Солнца, хромосферному и корональному нагреву, физике частично ионизированной плазмы, корональным выбросам массы и солнечным вспышкам.
Три других аппарата будут проводить измерения in situ для изучения космической погоды, создаваемой Солнцем в межпланетном пространстве, и получат ценные данные о температуре, скорости и плотности частиц и плазмы.
Основные научные задачи миссии включают в себя понимание коронального нагрева, выявление процессов, приводящих к солнечным вспышкам, изучение топологии магнитного поля в солнечной короне и определение факторов, влияющих на космическую метеорологию, таких как происхождение и динамика солнечного ветра.
Вклад ЕКА
ЕКА участвует в этой миссии двумя способами. Во-первых, в прошлом году оно оказало помощь ISRO в проверке нового важного программного обеспечения для динамики полета. Во-вторых, оно предоставит услуги связи через свою глобальную сеть станций слежения за дальним космосом.
Станции ЕКА будут поддерживать миссию от начала до конца: на критическом этапе запуска, во время полета к L1, а затем в течение последующих двух лет регулярной работы будут передавать команды и получать научные данные с Aditya-L1 в течение нескольких часов в день.
«Для миссии Aditya-L1 мы обеспечиваем поддержку со всех трех наших космических антенн в Австралии, Испании и Аргентине», — сказал Рамеш Челлатурай, руководитель службы ЕКА и сотрудник ЕКА по связям с ISRO. «Кроме того, мы оказываем поддержку с нашей станции Куру во Французской Гвиане и координируем поддержку с наземной станции Goonhilly в Англии».

Трудности на L1
Точки Лагранжа представляют собой стратегически выгодные позиции для полетов. В них гравитационные силы Солнца и Земли уравновешивают друг друга, поэтому космические аппараты могут работать с минимальным расходом топлива.
Наиболее известная точка Лагранжа — L1, расположенная между Землей и Солнцем, на расстоянии всего 1% от расстояния нашей планеты до Солнца. Это идеальное место для солнечных миссий, таких как Aditya-L1, поскольку оно обеспечивает непрерывный вид на Солнце, позволяя избежать земных затмений. Здесь уже вращается космический телескоп SOHO для наблюдения за Солнцем — совместная миссия ЕКА и НАСА, работающая с 1995 года.
Однако достижение L1 и поддержание орбиты вокруг нее является сложной задачей из-за нестабильности орбиты. Небольшие ошибки траектории могут быстро увеличиваться, что требует маневров для поддержания орбиты. Например, в 1998 году SOHO потерял связь из-за орбитальной ошибки, но был восстановлен благодаря сотрудничеству НАСА и ЕКА.
Именно поэтому ISRO обратилась к ЕКА за новым полетным программным обеспечением, которое гарантирует точность, необходимую для успешной работы на L1.